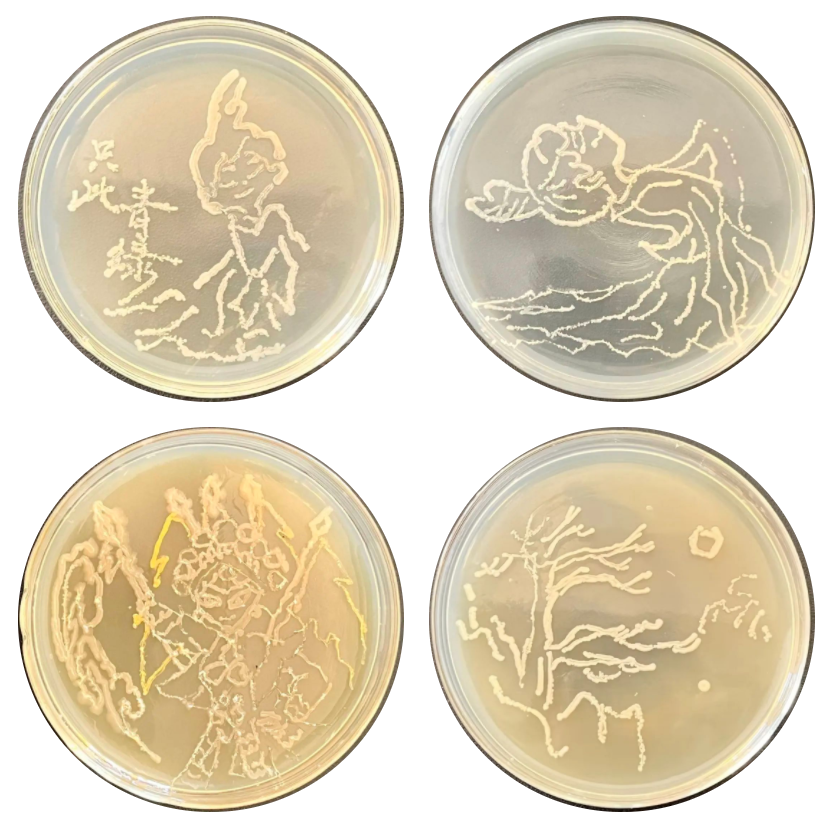
安师大附中学生作的画,脑洞大开!_微生物_项目_菌落

安师大附中黄燕

附属中学召开2021年春季学期第一次班主任工作会议-安徽师范大学
图片尺寸600x400
黄燕同志简历
图片尺寸500x701
黄燕讲授党史学习教育专题党课
图片尺寸800x559
成员 黄燕
图片尺寸500x750
黄燕
图片尺寸318x433
黄燕
图片尺寸925x1234
黄燕外语备课组
图片尺寸600x899
黄燕
图片尺寸3840x5760
安师大附中2017届高考成绩喜报 本科达线率
图片尺寸550x366
安师大附中入选教育部首批一校一案落实中小学德育工作指南典型案例
图片尺寸600x400
安师大附中学生作的画,脑洞大开!_微生物_项目_菌落
图片尺寸834x833
走,去安师大附中!_校友_校庆_芜湖市
图片尺寸1080x810
安师大附中保送清华学子戴玥探索生命世界的未知
图片尺寸500x333
总分653分安师大附中唐逸云文科芜湖市wuhushi总分699分合肥一中叶文
图片尺寸600x499
信息学奥赛省队名单公布 安师大附中7人进入前9 近日,第40届全国
图片尺寸440x330
求知探索共同成长模联协会赴安师大附中开展学术培训
图片尺寸1024x768
安师大二附中 | 你想了解的都在这里!
图片尺寸1280x852
安师大附中.怀念上万次都不够的地方#值得怀念的校园瞬间 #这 - 抖音
图片尺寸1920x1280
安师大附中2022届高三学生成人仪式暨高考百日誓师大会举行
图片尺寸600x600
芜湖校长说——安师大附中.#芜湖 #中考 #安师大附中 #教 - 抖音
图片尺寸1242x1660